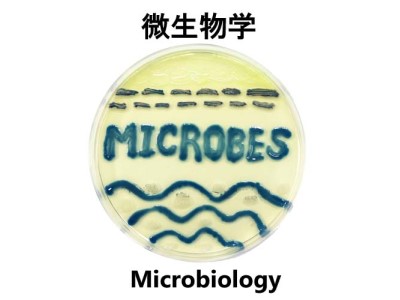

・各講座のアイコンが受験可能な課程です。
-

 神経発生学
神経発生学
Developmental Neurobiology教授 難波 隆志
View more
-

 分子病態解析学
分子病態解析学
Biomedical Molecular Sciences教授 髙橋 和男
View more
-

 分子腫瘍学
分子腫瘍学
Molecular Oncology教授 鈴木 元
View more
-

 分子病理学
分子病理学
Molecular Pathology教授 浅井 直也
View more
-

 ウイルス学
ウイルス学
Virology教授 村田 貴之
View more
-

 生理学
生理学
Physiology教授 長崎 弘
View more
-

 神経生理学
神経生理学
Neurophysiology教授 山下 貴之
View more
-

 生化学
生化学
Biochemistry教授 下野 洋平
View more
-

 薬理学
薬理学
Pharmacology教授 近藤 一直
View more
-

 公衆衛生学
公衆衛生学
Public Health教授 太田 充彦
View more
-

 予防医学
予防医学
Preventive Medicine教授 大神 信孝
View more
-
微生物学
微生物学
Microbiology教授 土井 洋平
View more
-

 法医学
法医学
Legal Medicine教授 磯部 一郎
View more
-

 医学教育学
医学教育学
Medical Education教授 大槻 眞嗣
View more
-

 医学教育開発学
医学教育開発学
Medical Education Research and Development教授 石原 慎
View more
-

 医事法・医療倫理学
医事法・医療倫理学
Medical Law and Ethics教授 飯島 祥彦
View more
-

 神経・腫瘍のシグナル解析学
神経・腫瘍のシグナル解析学
Neural and Tumor Signal Analysis教授 貝淵 弘三
View more
-

 分子遺伝学
分子遺伝学
Molecular Genetics教授 倉橋 浩樹
View more
-

 難病治療学
難病治療学
Therapies against Intractable Diseases教授 土田 邦博
View more
-

 システム医科学
システム医科学
Systems Medical Science教授 宮川 剛
View more
-

 医用データ科学
医用データ科学
Biomedical Data Science教授 吉本 潤一郎
View more
-

 神経行動薬理学
神経行動薬理学
Behavioral Neuropharmacology教授 永井 拓
View more
-

 腫瘍遺伝子制御学
腫瘍遺伝子制御学
Tumor and Gene Regulation教授 永野 修
View more
-

 先進がん免疫療法学
先進がん免疫療法学
Cellular Immunotherapies for Cancer教授 三原 圭一朗
View more


